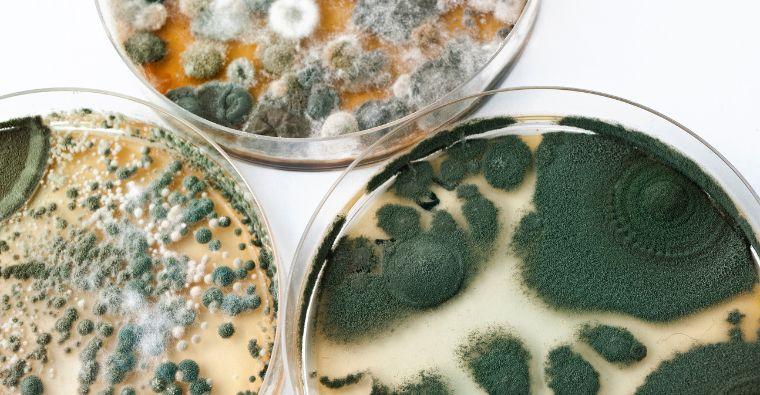
The Fascinating World of Mycology: Discovering the Importance of Fungi

Diversity of Fungi
Variety of Species: Fungi come in a staggering array of forms, from microscopic yeasts to towering mushrooms. There are over 100,000 known species, with many more yet to be discovered.
Ecological Roles: Fungi can be classified into different groups, including saprophytic (decomposers), parasitic (harmful to hosts), and mycorrhizal (symbiotic with plants), each contributing uniquely to their environments.
Ecosystem Functionality
Decomposers: Fungi play a critical role in nutrient cycling by breaking down organic matter, returning essential nutrients to the soil. This process is vital for ecosystem health and fertility.
Symbiosis with Plants: Mycorrhizal fungi form beneficial relationships with plant roots, enhancing water and nutrient uptake while receiving carbohydrates in return. This partnership is essential for the growth and survival of many plant species.
Culinary Uses
Mushrooms in Cuisine: Many fungi, such as mushrooms, are not only delicious but also nutritious. Varieties like shiitake, portobello, and chanterelle are prized for their flavors and health benefits.
Fermentation: Yeasts, a type of fungus, are essential in food production, particularly in bread-making and brewing. They convert sugars into alcohol and carbon dioxide, creating beloved products like beer and wine.
Medicinal Properties
Antibiotics and Antifungals: Fungi have been the source of many important medications, most notably penicillin, discovered by Alexander Fleming. This antibiotic revolutionized medicine and has saved countless lives.
Potential in Cancer Treatment: Research is ongoing into the use of certain fungi in developing cancer treatments, with compounds found in mushrooms showing promise in slowing tumor growth.
Environmental Indicators
Biodiversity Indicators: Fungi can serve as indicators of ecosystem health. Changes in fungal populations may signal shifts in environmental conditions, helping scientists monitor ecosystem changes and biodiversity.
Bioremediation: Some fungi can degrade environmental pollutants, making them valuable for bioremediation efforts. They can break down toxic substances in soil and water, helping to restore contaminated sites.
Cultural Significance
Folklore and Mythology: Fungi have inspired myths, legends, and art across cultures. From ancient civilizations that revered certain mushrooms to modern-day fascination with foraging, fungi hold a unique place in human culture.
Psychoactive Properties: Certain fungi, like psilocybin mushrooms, have been used for centuries in spiritual practices. Recent studies are exploring their potential therapeutic effects for mental health conditions, such as depression and anxiety.
Fungal Threats
Invasive Species: Some fungi can become invasive, harming local ecosystems and agriculture. Understanding their impact is crucial for conservation efforts and sustainable land management.
Pathogenic Fungi: While many fungi are beneficial, some can cause diseases in plants, animals, and humans. Monitoring these pathogens is essential for maintaining health in agricultural systems and public health.
The Future of Mycology
Research Opportunities: As scientists continue to explore the fungal kingdom, new discoveries promise to enhance our understanding of ecology, medicine, and biotechnology. The potential applications of fungi are vast and still largely untapped.
Citizen Science: Engaging the public in mycology through foraging clubs and educational programs can promote awareness and appreciation of fungi while contributing to scientific research.